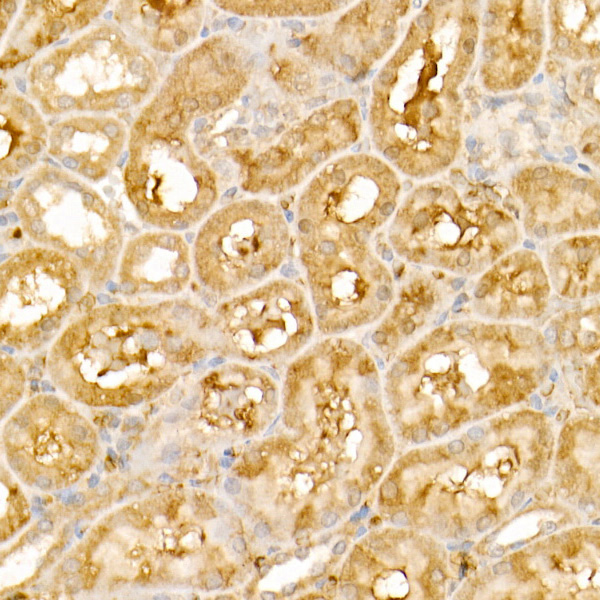

TRIM21 Rabbit Polyclonal Antibody
Other products for "TRIM21"
Specifications
| Product Data | |
| Applications | IF, IHC, IP, WB |
| Recommended Dilution | WB,1:500 - 1:2000 IHC,1:50 - 1:200 IF,1:50 - 1:200 IP,1:20 - 1:50 |
| Reactivities | Human, Mouse, Rat |
| Modifications | Unmodified |
| Host | Rabbit |
| Isotype | IgG |
| Clonality | Polyclonal |
| Immunogen | Recombinant fusion protein containing a sequence corresponding to amino acids 80-330 of human TRIM21 (NP_003132.2). |
| Formulation | Buffer: PBS with 0.02% sodium azide,50% glycerol,pH7.3. |
| Concentration | lot specific |
| Purification | Affinity purification |
| Conjugation | Unconjugated |
| Storage | Store at -20℃. Avoid freeze / thaw cycles. |
| Stability | Shelf life: one year from despatch. |
| Predicted Protein Size | 45kDa/54kDa |
| Gene Name | tripartite motif containing 21 |
| Database Link | |
| Background | This gene encodes a member of the tripartite motif (TRIM) family. The TRIM motif includes three zinc-binding domains, a RING, a B-box type 1 and a B-box type 2, and a coiled-coil region. The encoded protein is part of the RoSSA ribonucleoprotein, which includes a single polypeptide and one of four small RNA molecules. The RoSSA particle localizes to both the cytoplasm and the nucleus. RoSSA interacts with autoantigens in patients with Sjogren syndrome and systemic lupus erythematosus. Alternatively spliced transcript variants for this gene have been described but the full-length nature of only one has been determined. |
| Synonyms | RNF81; Ro(SS-A); RO52; SS-A; SSA; SSA1 |
| Reference Data | |
Documents
| Product Manuals |
| FAQs |
| SDS |
{0} Product Review(s)
0 Product Review(s)
Submit review
Be the first one to submit a review
Product Citations
*Delivery time may vary from web posted schedule. Occasional delays may occur due to unforeseen
complexities in the preparation of your product. International customers may expect an additional 1-2 weeks
in shipping.






























































































































































































































































 Germany
Germany
 Japan
Japan
 United Kingdom
United Kingdom
 China
China